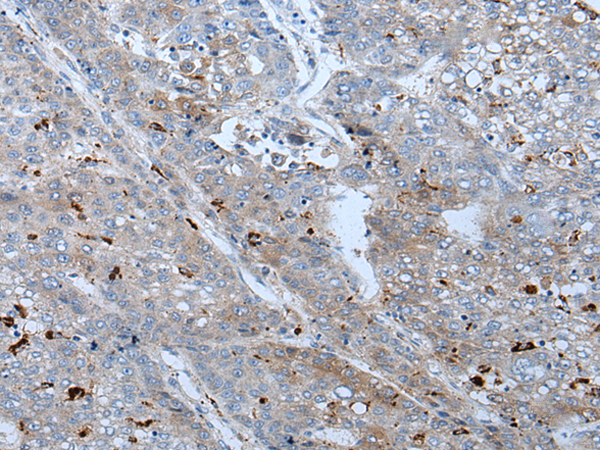

中文名稱: 兔抗BMP4多克隆抗體
|
Background: |
This gene encodes a member of the bone morphogenetic protein (BMP) family of proteins, which is part of the transforming growth factor-beta (TGF-beta) superfamily. Members of the BMP family play an important role in bone and cartilage development. The encoded preproprotein is proteolytically processed to generate each subunit of the disulfide-linked homodimer. Mutations in this gene are associated with orofacial cleft and microphthalmia in human patients. The encoded protein may also be involved in the pathology of multiple cardiovascular diseases and human cancers. Alternative splicing results in multiple transcript variants. |
|
Applications: |
ELISA, WB, IHC |
|
Name of antibody: |
BMP4 |
|
Immunogen: |
Synthetic peptide of human BMP4 |
|
Full name: |
bone morphogenetic protein 4 |
|
Synonyms: |
ZYME; BMP2B; OFC11; BMP2B1; MCOPS6 |
|
SwissProt: |
P12644 |
|
ELISA Recommended dilution: |
5000-10000 |
|
IHC positive control: |
Human liver cancer |
|
IHC Recommend dilution: |
20-100 |
|
WB Predicted band size: |
47 kDa |
|
WB Positive control: |
Hela cell lysate |
|
WB Recommended dilution: |
200-1000 |

購(gòu)物車
幫助
021-54845833/15800441009
